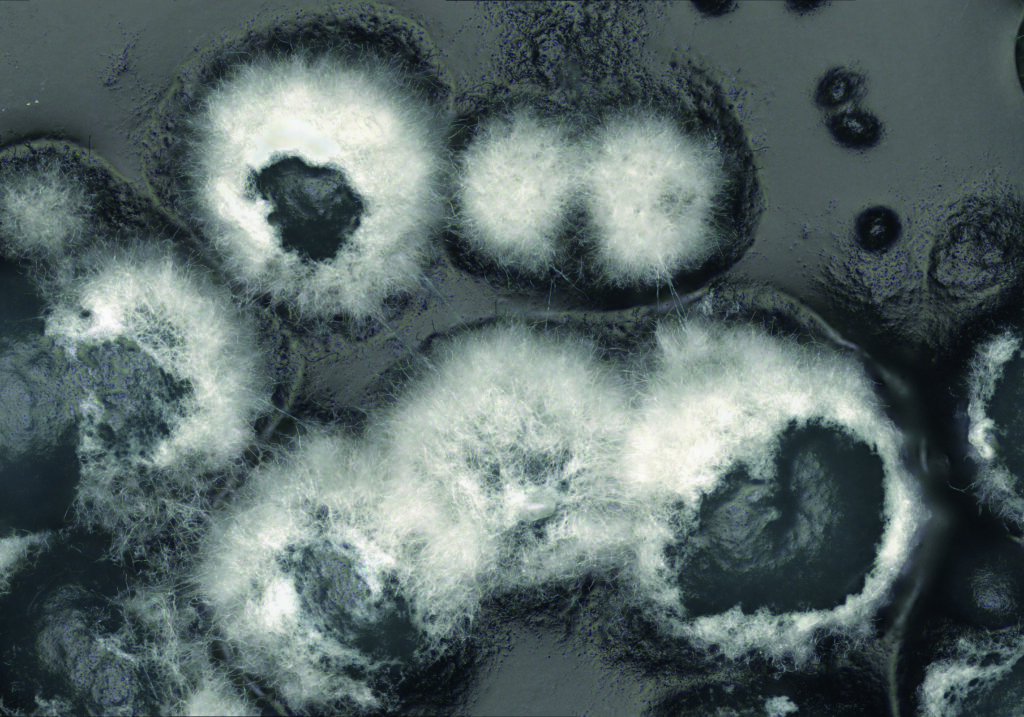
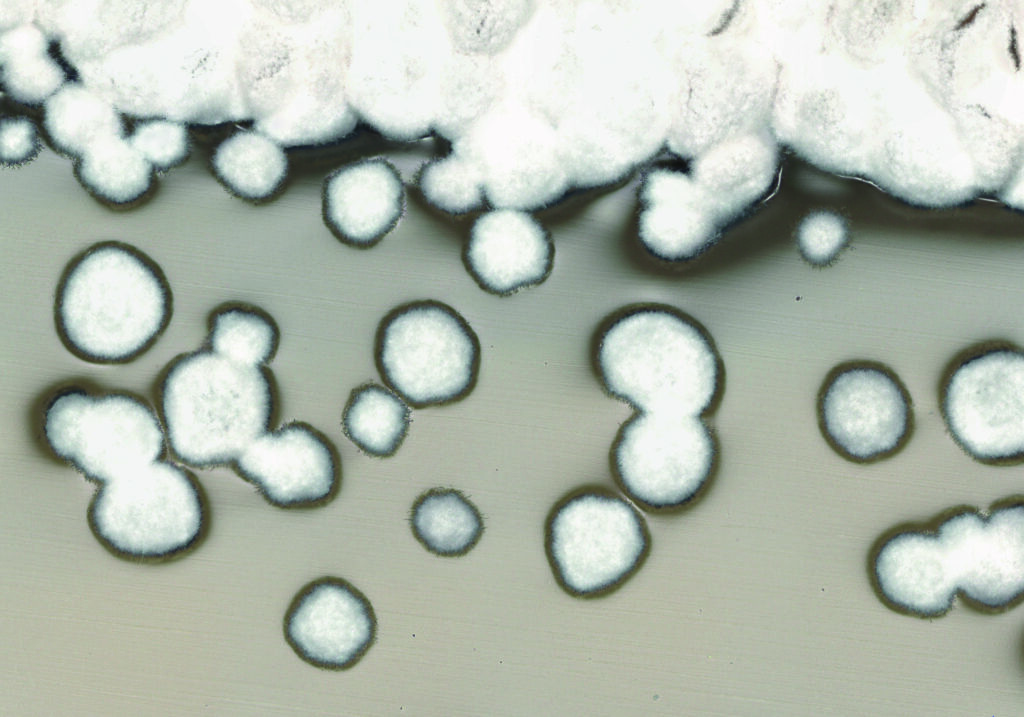

Whoa! What an incredible contests it has been!
We have received a staggering 113 artworks from 42 authors! From this artful cornucopia our association’s members selected 19 gems to be exhibited in Świdnicka street next to the Market Square. The exhibition will please the eyes of Wrocław residents until the 30th of September, while the remaining pieces will adorn the campus of Wrocław University of Science and Technology.
Not in Wrocław? Exhibitions have already finished? Don’t worry! You can return to the MANIAC 2025 participants and their submissions below in this post. We could not leave one masterpiece out!
Wait, wait, wait… Have we forgotten something? Gosh! Of course:
And 1st place of MANIAC 2025 goes to…

Sherlock Holmes on the Nano Trail by Nandhini Ravindran, University of Vienna
2nd place:

Cerebral Maniac by Priya Sagar, Wrocław University of Science and Technology
3rd place:

Frozen Lattice by Michał Ozga, Wrocław University of Science and Technology
We would like to thank all members of PhoBiA who contributed to the organization of the contest and exhibition. We also extend heartfetlt thanks to every participant who took the time to submit their work to our (no longer so) little competition. This gallery is for you!
Urszula Nawrot, Wrocław University of Science and Technology

About the author: Doctor at the Faculty of Electronics, Photonics and Microsystems, Department of Nanometrology
Works:

Golden Craters – The image shows an optical fibre attached with silver paste, underneath which there is an etched microchamber. The entire structure is coated with gold, but due to degradation, delamination of the gold is visible. The photo was taken with a PZO MST-132 stereoscopic microscope at 1.6× magnification.
Kinga Stempińska, Jan Dlugosz University in Czestochowa

About the author: My name is Kinga Stempińska, I am a cosmetologist and I study biotechnology. I am also starting my master’s degree in cosmetology. I am the chairperson of the MicroLab Microbiology Club, where I study the impact of plant extracts on skin microbiota bacteria in skin diseases. I am very interested in the impact of plants on the symptoms of skin diseases and I dream of developing my research in this direction.
Works:

Luminous Biofilm – Biofilm – DAPI staining, 1000× magnification, Olympus microscope with fluorescence attachment
Olaf Bajrak, Hirszfeld Institute of Immunology and Experimental Therapy, Polish Academy of Sciences

About the author: I’m a PhD student in Hirszfeld’s Institute of Immunology and Experimental Therapy Polish Academy of Sciences Bacteriophage Laboratory working as a “phage hunter”. My thesis is focused on the isolation of new bacteriophages and their biological characterisation. Despite that, in my free time, I’m involved in making music, feeding my three cats, and playing squash.
Works:

PhagePlosion – An electronogram made in transmission electron microscope probably showing bacteriophages (phages) attached do outer membrane vesicle (OMV). OMV are fragments of the outer membrane of bacteria, that can act as a decoy and protect pathogen from phage infection, preventing their adsorption to bacterial cell. Co-author MSc Norbert Łodej
Krzysztof Szopa, Faculty of Natural Sciences, University of Silesia

About the author: Geology is my passion. I am a petrologist at the University of Silesia in Katowice, Poland. I love nature, travelling, and photography.
Works:

Star ships – Image taken from a thin section of an igneous rock (cieszynite) under optical cathodoluminescence. The purple crystals are apatite, the blue ones are feldspars, and the orange ones are calcite.

Fingerprinted stone – Image taken from a thin section of a metamorphic rock under optical cathodoluminescence. The micro-zoning of quartz is clearly visible in the image.

A triangle within a triangle – Image taken from a thin section of quartz under optical cathodoluminescence. The image clearly shows crystal regeneration, dislocations, and chemical variability within the quartz. [My personal pick for top 3 – website editor 😉 ]

Space ball – Image taken from a thin section of a metamorphic rock under transmitted polarized light with crossed nicols. The photo shows a pyroxene chondrule from the Mt. Tazarzait meteorite.

Orange teeth – Image taken from a thin section of a metamorphic rock under optical cathodoluminescence. The orange-colored crystals are calcite.
(photo descriptions have been machine translated, please reach out to us if you’d like to clarify any terminology)
Krystian Sarat, Hirszfeld Institute of Immunology and Experimental Therapy, Polish Academy of Sciences

About the author: I am PhD student working in Hirszfeld Institute of Immunology and Experimental Therapy PAS. During my doctoral studies, my team and I are developing the first polish CAR-T cell therapy for the treatment of multiple myeloma.
Works:

Cell Warrior- This image shows a culture of CAR-T cells. A large cell aggregate (indicative of their activation) is visible, while the long tail is likely formed by dead cell debris. Microscope- Olympus CKX53.

Better Together- This image shows a CAR-T cell culture. Large cell aggregates are visible, and their presence, along with the cells elongated shape, indicates their activation. Microscope- Olympus CKX53.

In need of contact- This image shows a culture of NK cells. Elongated cells are visible, likely indicating an activated cell seeking interaction.Microscope- Leica Mateo FL.
Amal D. Premarathna, Tallinn University

About the author: A dedicated Biochemist researching the pharmaceutical and food applications of seaweed, with expertise in cell culture, animal models, and project design from hypothesis to research publication.
Works:

Cell-Cell Communication in HDF Culture – Microscopy image illustrating the interaction between adjacent human dermal fibroblasts. Their elongated processes are making contact, a key behavior in regulating population density and triggering proliferation.

Seaweed Polysaccharide Alters HDFs – Morphological and Behavioral Changes in HDFs Treated with red seaweeds: Chondrus crispus Polysaccharide

Intercellular Vesicle Trafficking in HDFs – High-magnification microscopy image showing two adjacent human dermal fibroblasts (HDFs). The bright, refractive punctate structures (arrows) localized at the cell-cell interface are suggestive of secretory vesicles. These vesicles are likely transporting signaling molecules (e.g., cytokines, growth factors), facilitating direct paracrine or juxtacrine communication between the cells.

Human Dermal Fibroblasts (HDF) Cells Secretory Function – HDFs are secretory powerhouses, producing collagen for structure, fibronectin for adhesion, and growth factors to instruct other cells.
Note: Images were acquired by fluorescence microscopy (ZEISS Axiovert 5) (40× objective). Live cells were stained with PhenoVue Hoechst 33342 – nuclear stain; PhenoVue Fluor 488 – Concanavalin A; PhenoVue Fluor 555 – WGA; PhenoVue Fluor 568 – Phalloidin; PhenoVue 512 – nucleic acid stain; PhenoVue 641 – mitochondrial stain.
Anna Zdubek, Wroclaw University of Science and Technology

About the author: My name is Anna Zdubek. I am a PhD student at the Faculty of Chemistry at Wrocław University of Science and Technology. My daily work involves the photodynamic destruction of bacterial pathogens.
Works:

The circle – Fluorescence microscope – microorganism cells

The onion skin – Fluorescence microscope – one layer of onion

Bacteria – Fluorescence microscope – bacterial cells
Marco Deiana, Institute of Advanced Materials, Faculty of Chemistry, Wrocław University of Science and Technology

About the author: I’m Marco Deiana, Assistant Professor at the Institute of Advanced Materials at WUST. After my PhD here, I worked as a postdoc at MIT in the US and at Umeå University in Sweden, where I also received fellowships including one with Nobel laureate Emmanuelle Charpentier. My current research focuses on understanding DNA structures in cancer cells and developing new light-based therapies to make photodynamic treatment more selective and effective, especially for hard-to-treat hypoxic tumors.
Works:

Solar Flare – Sample of diethyl 4,4′-azoxydibenzoate liquid crystal. Polarized Light Microscope.
Patrycja Zakrys, University College Cork

About the author: I am senior technical officer in School of Biochemistry and Molecular Biology. Microscopy work enthusiast.
Works:

Spheres – The Image shows fat globules distributed in dairy emulsion. It was captured using light microscope.
Małgorzata Małecka, Institute of Low Temperature and Structure Research, Polish Academy of Sciences

About the author: dr hab. Małgorzata Małecka, prof. INTiBS PAN – A chemist, a specialist in transmission electron microscopy. Her research focuses on the synthesis and analysis of nanomaterials and hierarchical catalysts based on cerium oxide.
Works:

The beauty of nanocrystals – Transmission Electron Microscope Philips CM20 Super Twin. High resolution image – Cerium oxide nanocrystallites

Electron microscopy – god’s eye – Transmission Electron Microscope Philips CM20 Super Twin. High-resolution image – the product of the reaction of ytterbium oxide and silica in a reducing atmosphere.

Hypnotizing order – Transmission Electron Microscope Philips CM20 Super Twin. Electron diffraction pattern – the product of the reaction of ytterbium oxide and silica in a reducing atmosphere.
Mathilda Ekholm, Université Côte d’Azur

About the author: I am a master’s student from Sweden, currently studying marine biology in France. This SEM photograph was taken during my internship at the Institute of Chemistry in Nice, where I worked on recycling bio-based thermoset plastics under the guidance of my supervisor, Nadir Lahfaidh.
Works:

The Microscopic Messenger – This scanning electron microscopy (SEM) image shows recycled cellulose fibers that were once part of a bio-plastic composite. Under high magnification, the intricate fiber structure unexpectedly formed the shape of an angel — a striking reminder of both material transformation and the surprising beauty within microscopic worlds.
Kamila Nowak, Wrocław University of Science and Technology

About the author: PhD student at WUST, member of Nanometrology Department
Works:

New life – SEM microscope image showing the semiconductor surface after the etching process.

Arabica coffee – SEM microscope image showing the semiconductor surface morphology.

Lungs – SEM microscope image showing the semiconductor surface morphology.

Mosaic – SEM microscope image showing the semiconductor surface morphology.
Weronika Nąckiewicz, Jan Długosz University in Częstochowa

About the author: I’m a second-year dietetics and first-year biotechnology student, and I’ve been interested in microbiology for about a year. I love sports, especially martial arts and volleyball.
Works:

Milky way – The photo shows milk kept in a warmer for 2 days.

Boxing gloves – The photo shows what’s inside a regularly used boxing glove.
Elżbieta Woźniak-Grygiel, Department of Histology, University of Opole

About the author: I am an academic teacher and laboratory diagnostician who enjoys inspiring my students with the beauty of the microscopic world of tissues.
Works:

Where Gold Comes Alive in Vision – Pannoramic MIDI II – an automatic digital slide scanner; 40x H&E; The human retina is a marvel of biological engineering, made up of ten intricate layers that an each single photon of light must navigate before we can see the world around us. Each layer, composed of specialized nerve cells, relays the signal, passing it forward like a neural relay race—ultimately sending the final message to the brain via the optic nerve.

Fungal Illusions: Pneumocystis in Bloom – LEICA DM1000 LED
Dawid Kubiak, Nicolaus Copernicus University in Toruń

About the author: I am a researcher in Biological Sciences, affiliated for the past 10 years with the Department of Cell and Molecular Biology at Nicolaus Copernicus University in Toruń. My work focuses on understanding how plants respond to abiotic stress at the molecular level, with a particular interest in hypoxia. Outside of the lab, I enjoy literature, sports, music, and photography, which fuel my curiosity and creativity in both professional and personal life.
Works:

Deeper – Root of narrow-leaved lupine imaged with three microscopes: light (methylene blue), confocal (polyA RNA – red, HOECHST – blue), and electron (lead citrate, uranyl acetate).
Krzysztof Wojno, Centre of Plasma and Laser Engineering, Institute of Fluid-Flow Machinery, Polish Academy of Sciences, Faculty of Applied Physics and Mathematics, Gdańsk University of Technology

About the author: Hi, I’m a nanotechnology student at PG and I’m currently completing my bachelor’s research at IMP PAN. I enjoy turning SEM images of my samples into art, as it allows me to share the hidden beauty of the nano-sized world with others. Universe is full of amazing things, look for them, be curious!
Works:

Trypophobia – The scanning electron microscopy image, which has been colorized, shows the top surface of spaced titania nanotubes formed by anodization of titanium foil.

Anchor – The scanning electron microscopy image, which has been colorized, shows a debris at the top surface of ordered titania nanotubes formed by anodization a Ti film sputtered on an ITO substrate. After anodization, thin metallic layers (15 nm Ag and 5 nm Cu) were sputtered onto titania, followed by calcination in hydrogen, resulting formation of Ag–Cu nanoparticles.

Desert – The scanning electron microscopy image, which has been colorized, shows the top surface of undeveloped titania nanotubes formed by anodization of Ti foil.

Pompeii – The scanning electron microscopy image, which has been colorized, shows the top surface of undeveloped titania nanotubes formed by anodization of a Ti foil.
Michalina Ślemp, Institute of Light and Matter, Université Claude Bernard Lyon 1

About the author: My name is Michalina Ślemp. I hold an MSc in Materials Engineering from the Wrocław University of Science and Technology (2022) and am currently pursuing a PhD at the Institut Lumière Matière in Lyon, France. During my time at Nanores, a company specializing in advanced material analysis with SEM microscopes, I had the chance to “play” with these instruments – capturing images that are not only scientifically valuable but also striking in their aesthetic beauty. Beyond the lab, my passions extend into the realms of art and horror & folklore, where I find inspiration in the interplay of beauty, tension, and the unseen.
Works:

Forest of Crystals – The DCNP crystal forest was produced using a new crystallization technique based on the Marangoni bursting phenomenon, where a droplet of isopropanol/water containing dissolved DCNP is spread rapidly over a substrate. As the more volatile alcohol evaporates, fingering instabilities generate many microdroplets in which DCNP precipitates, leading to the growth of fibers and dendrite-like crystalline structures
. This process yields flexible, forest-like assemblies of crystals and aggregates, including blue-emitting molecular aggregates that had been predicted by quantum-chemical calculations 12 years ago but had never been observed experimentally until my publication (J. Phys. Chem. C 2024, 128, 8, 3307–3317).

Forest in Nanoscale – Under the eye of the scanning electron microscope (SEM), a fascinating phenomenon reveals itself: when gold or platinum is sputtered onto a non-conductive material to improve its conductivity, a sufficient tilt can set atoms adrift, carried by ions, thus sculpting a surprising structure. Image taken in the company Nanores. [My personal pick for top 3 – website editor 😉 ]

Scoundrel – In this image, you see the intricate compound eye of a mosquito, framed by its delicate antennae. Using an environmental scanning electron microscope, which allows biological samples to be imaged without the destructive effects of high vacuum by maintaining a fine balance of water vapor, we could explore the insect in extraordinary detail. The story began when a colleague was bitten at work; in playful revenge, we captured the mosquito, kept it alive in a container until it passed naturally, and then placed it under the microscope. We hoped to find traces of blood inside its proboscis, the specialized needle-like mouthpart used to pierce skin, but by then the cells had already been digested. However, I must admit that its eyes seem to show remorse.
Wojciech Szlauer, University of Wrocław

About the author: I have a master’s degree in microbiology and am currently working and pursuing a doctorate at the University of Wrocław. Nature observation has been a long-time hobby of mine. I admire nature through a telescope and binoculars, and the natural world beneath our feet through a microscope.
Works:

Frost – Long crystals of potassium dihydrogen phosphate in bright field microscope with polarization filters.

Green World – Leaf of water plant from Sołtysowicki Forest. Bright field microscope.

Roots of Light – Root of water plant from Sołtysowicki Forest, with visible polymer fiber. Bright field microscope with polarization filter.

Polarized Aim – Crystal of magnesium sulfate in old polarized light microscope.

Starry Night – Fern spores in dark field microscope.
Julia Zając, Institute of Materials Engineering, Faculty of Science and Technology, University of Silesia

About the author: I am a PhD student at International Environmental Doctoral School at University of Silesia in Katowice. On daily basis I focus on the development and research of new alloys for medicine. Beyond the lab, I’m a passionate gamer and anime fan, enjoyer of LEGO and card collecting, but also – suprisingly – a sport enthusiast. I am equally captivated by the natural world – an avid animal lover and dedicated ornithologist, constantly discovering new wonders about creatures around me. Despite my many interests and responsibilities, I always make time for my loved ones, who support me at all times.
Works:

The hen that laid the golden eggs – The picture was taken using metallographic microscope and shows a close-up of a ring’s ornament, which resembles chicken’s foot. The title whimsically alludes to a traditional Polish idiom.

Reminiscence in metal – The photo was taken using optical metallographic microscope and shows unconventional forms resulting from decorative engraving of jewelry. The golden colour emphasises a nostalgic character, reinforcing the theme of “Reminiscence in metal”.

Primordial resurgence – The image taken with metallographic microscope, presents a copper-alloy ring, crafted to imitate golden jewelry. Time and wear have gradually erased its outer layers, revealing its true essence beneath – the raw surface now veiled in a green patina, a quiet testimony to its transformation and history.

An unforeseen collision – The image, obtained using scanning electron microscope, shows agglomerated molybdenum powder. Countless particles, drawn together in seemingly chance encounters, form intricate structures.

Dragonfly in the grain – The image, obtained using scanning electron microscope, presents the microstructure of a Zr-Nb-Mo alloy after water quenching. The arrangement of grains intriguingly resembles a dragonfly in flight, with the title “Dragonfly in the grain” playfully connecting the scientific terminology with an artistic expression.
Waseem Ahmad Wani, University College Dublin

About the author: I am Waseem Ahmad Wani, working in the field of nanofunctional materials at UCD, with expertise in Atomic Force Microscopy (AFM)
Works:

Ferroelectric domain pattern written on hafnia thin films – Ferroelectric domain pattern on hafnia thin films, written using a 20 nm radius electrical probe and imaged via Piezoelectric Force Microscopy over a 20 µm scan area.
Jan Pytel, Institut de Biologie de l’École Normale Supérieure (IBENS), École Normale Supérieure, Université PSL [pardon my French]

About the author: I am an alumnus of Wrocław University of Science and Technology and currently a PhD student at Institut de Biologie de l’École Normale Supérieure in Paris. My scientific interests revolve around the application of pulsed lasers for spectroscopy and bioimaging. In my free time I enjoy reading science-fiction and non-fiction books, as well as hiking and ice skating.
Works:

Space Invaders – Droplets of MBBA liquid crystal under a polarized light microscope during cooling. The liquid crystal was introduced between two grooved coverslips assembled perpendicularly.
Paulina Gregorczyk, Department of Medical Biotechnology, Faculty of Biotechnology, University of Wroclaw

About the author: I am a PhD student at the Doctoral College of Biomedical Sciences, University of Wrocław. My research focuses on the transport and function of the intracellular fibroblast growth factor receptor 1 (FGFR1) and its role in regulating gene expression.
Works:

There is Love out there in the universe – Human osteosarcoma cells (U2OS cell line) stained with mitochondrial marker (green fluorescence) and nucleus stained with DAPI (blue fluorescence). Photo was taken using Opera Phenix Plus High-Content Screening system (Perkin Elmer, Waltham, MA, USA) and 63X objective. If you look closely, you can notice a heart-shaped signal within the green fluorescence.

Traveling together through the galaxies – Human osteosarcoma cells (U2OS cell line) stained with mitochondrial marker (green fluorescence) and nucleus stained with DAPI (blue fluorescence). Photo was taken using Opera Phenix Plus High-Content Screening system (Perkin Elmer, Waltham, MA, USA) and 63X objective.
Zuzanna Sycz, Institute of Medical Sciences, University of Opole

About the author: microbiology enthusiast
Works:

FROZEN – For visualization by fluorescence microscopy (microscope: Nikon Eclipse 400, magnification: 1000-fold) the Escherichia coli biofilms were allowed to grow on polystyrene pieces (0.5×0.5 cm), after 24 h incubation were superinfected with Pseudomonas aeruginosa strain, and then after 96 h such 2-species biofilms were stained with DAPI (4’,6-diamidino-2-phenylindole) solution.
Anna Tuwalska, Nicolaus Copernicus University in Toruń

About the author: PhD candidate at the Academia Copernicana at the Nicolaus Copernicus University in Toruń, working on biomaterials and scaffolds for bone cell growth
Works:

Meteoroid – Quanta 3D FEG

Stars of science – JEOL JSM5410 (Tokyo, Japan)
Co-authors: Jolanta Wółkiewicz (Nicolaus Copernicus University); Jan Czarnecki (Jagiellonian University). Grzegorz Tylko (Jagiellonian University)
Maja Maciaszczyk, Państwowe Liceum Plastyczne im. Jacka Malczewskiego w Częstochowie

About the author: I’m 19 years old artist fascinated by the world of nature.
Works:

Scales1 – Microscope Delta Optical Biolight 300, Marbled White butterfly wing.

Scales2 – Microscope Delta Optical Biolight 300, Marbled White butterfly wing.

Scales3 – Microscope Delta Optical Biolight 300, Privet Hawk Moth wing.
Damian Szymański, Institute of Low Temperature and Structure Research, Polish Academy of Sciences

About the author: Assistant professor at the Department of Nanomaterials Chemistry and Catalysis, which is part of the Institute of Low Temperature and Structural Research, Polish Academy of Sciences in Wrocław. Since 2017, he has been researching functional materials (including catalytic, magnetic, superconducting and luminescent materials) using scanning electron microscopy (SEM). His scientific interests lie in the field of luminescent materials doped with rare earth ions, energy transfer mechanisms and nanomaterials.
Works:

Surface of a wasp’s wing – The SEM image shows the surface of the wing of a common wasp (Vespula vulgaris) with visible sensory hairs (called setae). These types of sensors function as microscopic detectors that detect air movement and touch, and assist in precise flight control.

Diatomaceous earth from Algeria – The SEM image shows diatomaceous earth (diatomite) from Algeria. Diatomaceous earth is a natural, porous mineral composed of microscopic diatom shells, rich in silica. Due to its absorbent, abrasive and insecticidal properties, it is used in agriculture, filtration, cosmetics and environmental protection.

NaYF4 hexagonal crystals – The SEM image shows hexagonal NaYF4 crystals. NaYF₄ (sodium yttrium fluoride) is often used as a host material in luminescent and laser materials. It is characterized by low optical loss and chemical stability, which makes it an ideal host for rare earth (RE) ions.
Nandhini Ravindran
Physics of Nanostructured Materials, University of Vienna

About the author: I am a microscopist. I explore atoms using the super cool Nion UltraSTEM 100 (Scanning Transmission Electron Microscope). As a doctoral student in Physics, I am learning a lot about the world of physics and would like to eventually contribute in a meaningful way towards the building of a sustainable, safe and friendly society/world.
Works:

Sherlock Holmes on the Nano Trail – The aberration-corrected ultra-high vacuum scanning transmission electron microscope Nion UltraSTEM 100 was used to capture the image. It is a bright field image of a free-standing hexagonal boron nitride (hBN) on a transmission electron microscope grid (TEM). The image shows Sherlock Holmes on the quantifoil on a nano trail.

Radiating Nano Carpet – Nion UltraSTEM 100 microscope was used to capture MoS2 on Graphene (vdW heterostructure- MAADF image) that resembles a radiating carpet in the nano world due to its lattice orientation by forming a moire’ pattern.

Yes, nanoporous silica 30 nm can be a mosaic too – Nion UltraSTEM 100 microscope was used to capture a 30 nm thick nanoporous silica membrane that looks very much like a mosaic tile from the 1960s. A mosaic nano floor.

Nano Skull Candy – Nion UltraSTEM 100 was used to capture MoS2 on Graphene (vdW heterostructure- MAADF image). Yet another moire’ pattern forming an artistic nano skull candy lattice.

Another universe – invisible and nano – Nion UltraSTEM 100 was used to capture a free-standing hBN on TEM grid. The photo is one of the holes of the hBN covered quantifoil forming a universe filled with nano galaxies.
Michał Ozga, Wrocław University of Science and Technology

About the author: I am a first year doctoral student at Politechnika Wroclawska, under supervision of Prof. Agnieszka Baszczuk and Prof. Agata Lamacz, in the field of Materials Engineering, and my interests are composites of metal-organic frameworks, with metal oxides. In the free time, I like to travel and photograph nature.
Works:

Blue Donut – – SEM/HITACHI S-3400N/2007 Electronic Scanning Microscope, a picture of a sample of the soil, used for morphological measurement at the SPEED Project (10.0kV, 9.8mm, x6000 zoom). [Holy cow! My personal pick for top 3 – website editor 😉 ]

Echoes of Ice – SEM/HITACHI S-3400N/2007 Electronic Scanning Microscope, a picture of a composite of HKUST-1 with titanium dioxide (10.0kV, 9.7mm, x4000 zoom).

Frozen Lattice – SEM/HITACHI S-3400N/2007 Electronic Scanning Microscope, a picture of a composite of HKUST-1 with titanium dioxide (10.0kV, 9.6mm, x1500 zoom).

Shard of Time – SEM/HITACHI S-3400N/2007 Electronic Scanning Microscope, a picture of a titanium dioxide particle (10.0kV, 11.5mm, x100 zoom).

Solar Reef – SEM/HITACHI S-3400N/2007 Electronic Scanning Microscope, a picture of a composite of HKUST-1 with titanium dioxide (10.0kV, 10.6mm, x1000 zoom).
Kseniya Gientka, Warsaw University of Technology

About the author: A biotechnology student who discovers beauty in the microscopic details of life. Her photographs reveal how science and imagination can intertwine, turning cells and structures into works of art. Beyond research, she embraces gothic fashion and expressive makeup, while her free time is filled with aquariums and cultivating a small terrace garden.
Works:

Velvet Echoes of Mullein – The image was taken using a light microscope at 100 magnification. It shows the waxy coating on the surface of mullein leaves.

Silent Geometry of Mucor – Captured under a light microscope at 50 magnification, this image displays the hyphae and sporangia of the Mucor fungus.

Pumpkin’s Verdant Spine – The image was taken with a light microscope at 125 magnification and shows the anatomical structure of a pumpkin stem.

The Cat’s Hidden Orbit – Captured under a light microscope at 100 magnification, this image reveals a Graafian follicle in a cat’s ovary.

Ciliary Ballet of Cells – The image was obtained using a light microscope at 100 magnification, showing ciliated epithelial cells.
Natalia Królica, University of Silesia

About the author: Hi! I’m Natalia. I am a chemistry student at the University of Silesia. My interests include the natural sciences and, more broadly, art in all its forms.
Works:

Blooming Darkness – The photograph presents the dissolution process of rosaniline hydrochloride in a glycerin medium. The image was obtained using an ECLIPSE E600 Pol polarizing microscope by Nikon.

Luminous Circle – The photograph shows crystals of ascorbic acid observed under polarized light. The image was taken using an ECLIPSE E600 Pol polarizing microscope by Nikon.
Adrianna Cieślak, Wrocław University of Science and Technology

About the author: PhD Student at the Faculty of Mechanical Engineering, Department of Mechanics, Materials and Biomedical Engineering, Wrocław University of Science and Technology. Her research interests include bioengineering, biomaterials, and additive manufacturing.
Works:

Spaghetti alla Scienza – Digital microscope KEYENCE VHX-500FE, 20x magnification. Microscopic image of a flow microchannel (channel width is 1 mm) resembling fantastic Italian spaghetti pasta but with a scientific twist! It is created by imprinting a meandering stamp into a hydrogel with carbon nanotube (CNT) as a substrate. Time to try a fantastic Italian scientific speciality!

Slytherin – Digital microscope KEYENCE VHX-500FE, 20x magnification. Microscopic image of a flow microchannel (channel width is 1 mm) resembling Salazar Slytherin’s snake created by imprinting a meandering stamp into a hydrogel with CNT as a substrate. Who knows, maybe He will take you to his school.

Odbicie Nauki – Digital microscope KEYENCE VHX-500FE, 20x magnification. A mechanical gear and a meandering channel are reflected in the hydrogel. As You can see, reflections are not only in the mirror; they can also be captured in many interesting materials.
Co-authors: Michał Żółtowski (PhD Student at the Faculty of Electronics, Photonics and Microsystems, Department of Microsystems, Wrocław University of Science and Technology. His research interests include electronics and 3D printing in vacuum applications.), Agnieszka Krakos (Doctor of Engineering at the Faculty of Electronics, Photonics and Microsystems, Department of Microsystems, Wrocław University of Science and Technology. Her research interests include lab-on-chip devices, space microengineering, and biomedical engineering.)
Ewelina Ksepko, Wrocław University of Science and Technology

About the author: I am Ewelina Ksepko, working as an academic teacher and tutor at the WUST Chemistry Faculty. The work presented here is the result of Mateusz Miller’s master’s thesis on environmentally friendly oxygen carriers used for energy generation, which I supervised.
Works:

A heartfelt heart amidst the bustling crowd – The solid oxygen carriers contain iron and manganese oxides for chemical looping fuel combustion applications. The photo was made with the SEM JSM-6610 LV microscope by JEOL.
Maja Kostrzewa, Polish Collection of Microorganisms, Hirszfeld Institute of Immunology and Experimental Therapy, Polish Academy of Sciences

About the author: I am an MSc Eng in Biotechnology and a graduate of the Wrocław University of Science and Technology. Currently, I work at the Polish Collection of Microorganisms, where I combine my scientific background with a strong interest in bioimaging. Through microscopy, I explore the hidden beauty of the microbial world, aiming to showcase the connection of science and art.
Works:
Holding Together – Colonies of Streptomyces griseus PCM 2331 growing on medium plate under VHX-X1 digital microscope in reflected light with depth composition.
Cotton Clouds – Colonies of Pseudonocardia autotrophica PCM 2186 growing on a medium plate. Photo taken on VHX-X1 digital microscope in reflected light mode with depth composition.

The Milky Way – Bacterial biomass of Serratia plymuthica PCM 550 growing on a nutrient agar plate. Photo taken on VHX-X1 digital microscope in reflected light with depth composition.
Amelia Maj, Wrocław University of Science and Technology

About the author: I am a first-cycle student at the Faculty of Chemistry. My scientific interests include: intersection of chemistry and biology, applications of electron microscopy in biology and medicine, TEM.
Works:

Soap bubble – polarized light microscope, MBBA

Cartoon magic – polarized light microscope, ternary system AOT + p-xylene + water

Nature is watching you – polarized light microscope, 8CB + COC (cholesteryl oleyl carbonate)

Liquid-crystalline mitochondria – polarized light microscope, 8CB in CTAB

Beneath the waves: Jellyfish waltz – polarized light microscope, 8CB in CTAB
Aadarsh Kumar, University College Dublin

About the author: I’m currently pursuing a PhD at the School of Physics, University College Dublin, focusing on amyloids topographical and mechanical properties using AFM.
Works:

Symmetry in Disorder – Internal structure of an amyloid using Atomic Force Microscope.
Maja Ducka, Wrocław University of Science and Technology

About the author: My name is Maja and I’m a PhD student at Wrocław University of Science and Technology. My interests include additive manufacturing, smart materials and hydrogels.
Works:

Brain wave – ZEISS EVO MA25 scanning electron microscope. 3D printed alginate/chitosan hydrogel scaffold, coated in pectin, dried.

Elephant’s skin – ZEISS EVO MA25 scanning electron microscope. 3D printed alginate/chitosan hydrogel scaffold, coated in pectin, dried.

Eyjafjallajökull’s eruption – ZEISS EVO MA25 scanning electron microscope. 3D printed alginate/chitosan hydrogel scaffold, dried.

Mycelium attack – ZEISS EVO MA25 scanning electron microscope. 3D printed alginate/chitosan hydrogel scaffold, coated in pectin, dried.
Co-author: Maria Skrodzka
Paula Śwituszak-Żywica, Nicolaus Copernicus University in Toruń

About the author: PhD student at the Doctoral School Academia Artium Humaniorum at Nicolaus Copernicus University in Toruń (Poland), working at the field of art conservation and heritage science. Passionate about exploring historic objects from every possible angle — especially through the lens of scientific imaging, microscopy, and analytical techniques.
Works:

RYBCIA “Little Fish” – KEYENCE VHX-7000N A sample of a paint layer taken from a historic painting looks as colourful as an underwater coral reef. The image shows a fragment with remnants of gilding and a striking blue “eye” made from the most precious pigment in the world: lapis lazuli.

EMERALD – KEYENCE VHX-7000NA copper plate and orpiment (As₂S₃) after undergoing ageing tests in fluctuating temperature and humidity conditions, they revealed true mesmerisingly green treasure.
Paweł Kudrys, University of Opole

About the author: Academic teacher of histology
Works:

Caenorhabditis elegans A Last Whisper of Life – Olympus CX23

Conidiogenesis of Alternaria A Microscopic Perspective – Olympus CX23

Seeds of Survival The Spore Dimension – Olympus CX23

The Dance of the Caenorhabditis elegans – Olympus CX23
Priya Sagar
Wrocław University of Science and Technology

About the author: Hi! I am Priya Sagar, a master’s student exploring the world of science at intersection of nanomaterials and biology to design solutions for health and environmental challenges.
Works:

The WOMB – Neural motherhood through self-assembly of myelin stained with rhodamine -presenting a sacred chamber-of feminine energy and genesis. OLYMPUS BX-60 POLARISED LIGHT MICROSCOPE

CEREBRAL MANIAC – A chaotic bloom of PhD mind with spiralling and coiling ideas, that branches endlessly-presented by PC (phosphatidylcholine) hydrated with electrolytes. OLYMPUS BX-60 POLARISED LIGHT MICROSCOPE

THE RING – The haunting circle of neural curse presenting a geometry of continuity and self-assembly after perspiration. OLYMPUS BX-60 POLARISED LIGHT MICROSCOPE
Aleksandra Nadolska, University of Łódź

About the author: I am a PhD candidate at the University of Lodz, studying resistive switching in ultrathin 2D transition metal oxides. This research aims to understand how these materials can be used for future memory devices and neuromorphic computing.
Works:

Steps of Cheops – What looks like an ancient pyramid is, in fact, a nanoscale pyramid of 2D molybdenum trioxide (MoO₃). Grown through screw-dislocation-driven processes, the crystal forms regular steps (each step is 0.7 nm thick) that resemble the terraces of a pyramid. Captured with atomic force microscopy in phase mode, the image reveals how nature’s growth mechanisms can create matter at the nanoscale into such remarkable forms. [My personal pick for top 3 – website editor 😉 ]

Frozen Waves – Seen through an optical microscope, thin layers of 2D molybdenum trioxide (MoO₃) spread across the surface of highly ordered pyrolytic graphite (HOPG) like a frozen wave. The oxide tends to grow preferentially along the edges of the substrate, giving rise to the striking wave-like patterns.

Under the Mountains – Under the optical microscope, folded flakes of highly ordered pyrolytic graphite (HOPG) rise like dark mountains. At their base, two-dimensional crystals of molybdenum trioxide (MoO₃) cluster together, forming what looks like a small village beneath the peaks.
Paweł Cwynar, Wrocław University of Science and Technology

About the author: I am a PhD student working on a project focused on sensing water pollutants. Beyond my scientific interests, I am passionate about cinematography, especially classic films, and I enjoy discovering the beauty of Lower Silesia through my travels. I also have a dog and a cat, and I particularly enjoy taking long walks with my dog along the banks of the Odra River.
Works:

Creation of Man – Alginate/Chitosan hydrogel under cross polarizers

Archipelago – Alginate/Chitosan hydrogel

The Eye of Light – MOF crystal

Hells blade – MOF crystal
Dofinansowano ze środków Gminy Wrocław w ramach programu Fundusz Aktywności Studenckiej (FAST), organizowanego przez Wrocławskie Centrum Akademickie.
Co-financed by the city of Wrocław as part of the Student Activity Fund (FAST), organised by the Wrocław Academic Centre.
